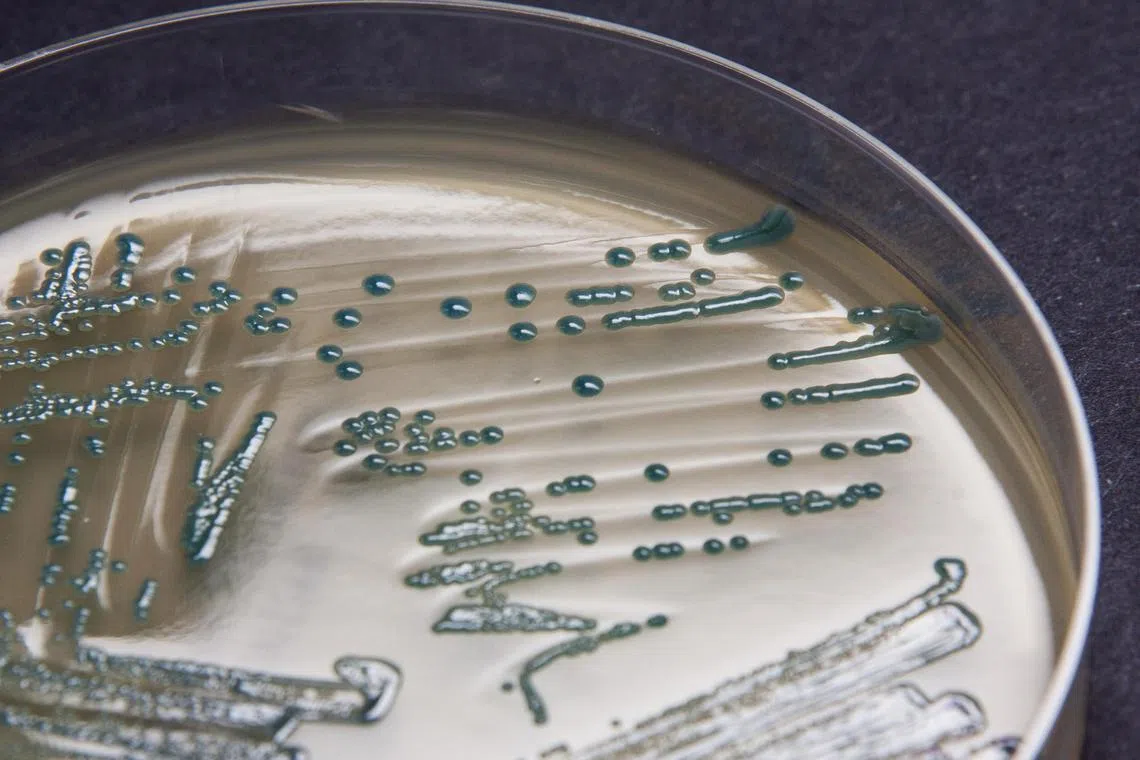
Colonies of carbapenem-resistant Enterobacteriaceae on a screening agar plate.

S’pore research team gets $10m grant to fight drug-resistant superbugs
Sign up now: Get ST's newsletters delivered to your inbox
Colonies of carbapenem-resistant Enterobacteriaceae on a screening agar plate.
PHOTO: SGH DEPARTMENT OF MICROBIOLOGY
SINGAPORE – A team of researchers here has been granted $10 million for a five-year project to find ways to fight superbugs or drug-resistant bacteria, which cause infections that are difficult to treat with existing antibiotics.
Globally, there has been a rise in bacterial infections that do not respond to carbapenem antibiotics, which are potent and often used as a last-resort treatment.
In Singapore, carbapenem-resistant bacteria are confined to the hospitals. There are more than 1,500 carbapenem-resistant infections here each year, accounting for approximately 30 deaths and more than 1,000 excess hospital bed-days, as those infected required longer hospital stays.
However, in several countries – especially in South Asia – these bacteria are infecting people in the community as well, said Professor Hsu Li Yang, corresponding principal investigator in the AntiMicrobial Resistance Research and Intervention Alliance Singapore (Amritas) team conducting the study.
Hundreds of preventable deaths occur in Asia and Singapore each year as a result of carbapenem-resistant bacterial infections (CR-GNB), added Prof Hsu, the vice-dean of global health at the National University of Singapore’s (NUS) Saw Swee Hock School of Public Health.
These are caused by the most antibiotic-resistant bacteria that top the World Health Organisation’s (WHO) priority list for antimicrobial resistance, he said. They are transmitted between people through close contact, or through food sources on rare occasions, and found in the environment.
“Clinicians lack evidence to guide the best treatment choice for their patients, as well as tools to prevent infection spread,” Prof Hsu added.
The Amritas team will be using the $10 million grant from the National Medical Research Council to address this healthcare gap.
The team members are from NUS’ Saw Swee Hock School of Public Health and Yong Loo Lin School of Medicine, Genome Institute of Singapore, National Centre for Infectious Diseases, Lee Kong Chian School of Medicine, Singapore General Hospital, Singapore Clinical Research Institute and National University Hospital, and also include expert collaborators from top regional institutions.
They will be working towards new solutions that are required, including deciding on the best treatments, as well as finding out how to prevent the bacteria from being established in the guts of unsuspecting patients, said Prof Hsu.
There are two parts to the Amritas programme.
In the first part, the researchers will recruit local and overseas patients with carbapenem-resistant bacterial infections to test various antibiotic treatment regimens to see which ones work best.
Overseas patients will be recruited through a Singapore-headquartered global clinical trial network called Advance-ID that connects 60 hospitals in more than 20 countries.
In the second part, the researchers will study the factors that affect the transmission of these bacteria in the gut and then find ways to prevent them.
Carbapenem resistance can be found in common gut bacteria such as E. coli, among the trillions of other gut bacteria. These carbapenem-resistant bacteria can colonise the human gut and do not cause infections until the gut lining is disrupted or the immune system is weakened, said Prof Hsu.
“However, they serve as silent reservoirs for further spread to other individuals or the environment,” he said.
Antimicrobial resistance (AMR) is an urgent global health problem, as extremely resistant pathogens are becoming more common. WHO has declared antimicrobial resistance, which makes common infections harder to treat and increases the risk of disease spread, as one of the top 10 global public health threats.
A study published in The Lancet reported that bacterial antimicrobial resistance was associated with an estimated 4.95 million deaths worldwide in 2019, of which 1.27 million were a direct result of such resistance.
The Amritas programme was launched at the Collaborative Solutions Targeting AMR: Research Symposium on Nov 16.
If the research is successful, the team would have made significant breakthroughs in how best to test antibiotic treatments and how drug-resistant bacterial colonisation may be blocked in the gut, Prof Hsu said.



